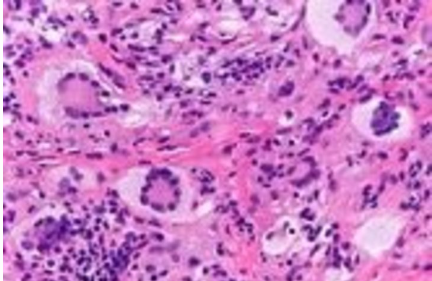
Flashcard 1 image

The histopathological section has giant cells with a central ring of nuclei suggestive of _____
What type of cells are the following examples? _____ ,smooth muscle cells
Hint: Labile, Stable, or Permanent?

Keloid scars are characterized by very increased type _____ and III collagen synthesis
Acute inflammation typically results in resolution and healing, which is mediated by _____ and TGF-B
Silica may impair _____ and disrupt phagolysosome formation, increasing susceptibility to TB
Vitamin D excess is seen in _____ diseases due to increased activation of vitamin D by epithelioid macrophages
_____ and VCAM-1 are cellular adhesion molecules that are upregulated on endothelium during leukocyte adhesion
Chronic disease results in _____ hepcidin release from the liver
Lymph node biopsy in _____ disease reveals stellate granulomas resembling those seen in sarcoidosis
_____ -selectin expression is induced by IL-1 and TNF
Acute Inflammation: Vascular Events
Flashcards
Acute Inflammation: Cellular Events
Flashcards
Chemical Mediators of Inflammation
Flashcards
Chronic Inflammation
Flashcards
Granulomatous Inflammation
Flashcards
Systemic Effects of Inflammation
Flashcards
Wound Healing
Flashcards
Tissue Regeneration
Flashcards
Fibrosis and Repair
Flashcards
Resolution of Inflammation
Flashcards
Get full access to all flashcards, spaced repetition, and progress tracking.
Start For Free